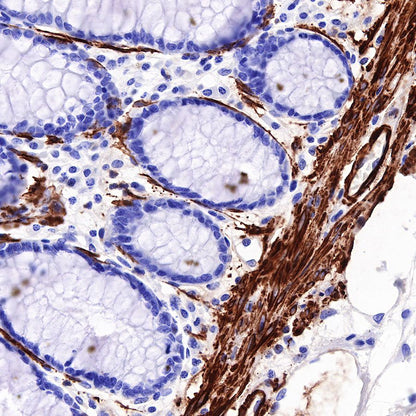
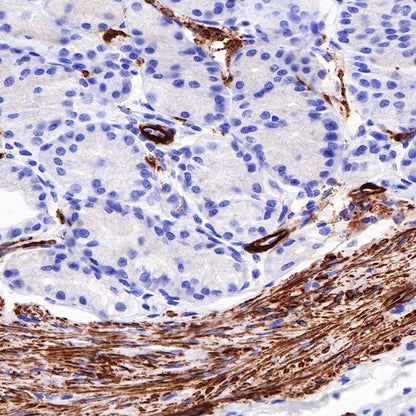
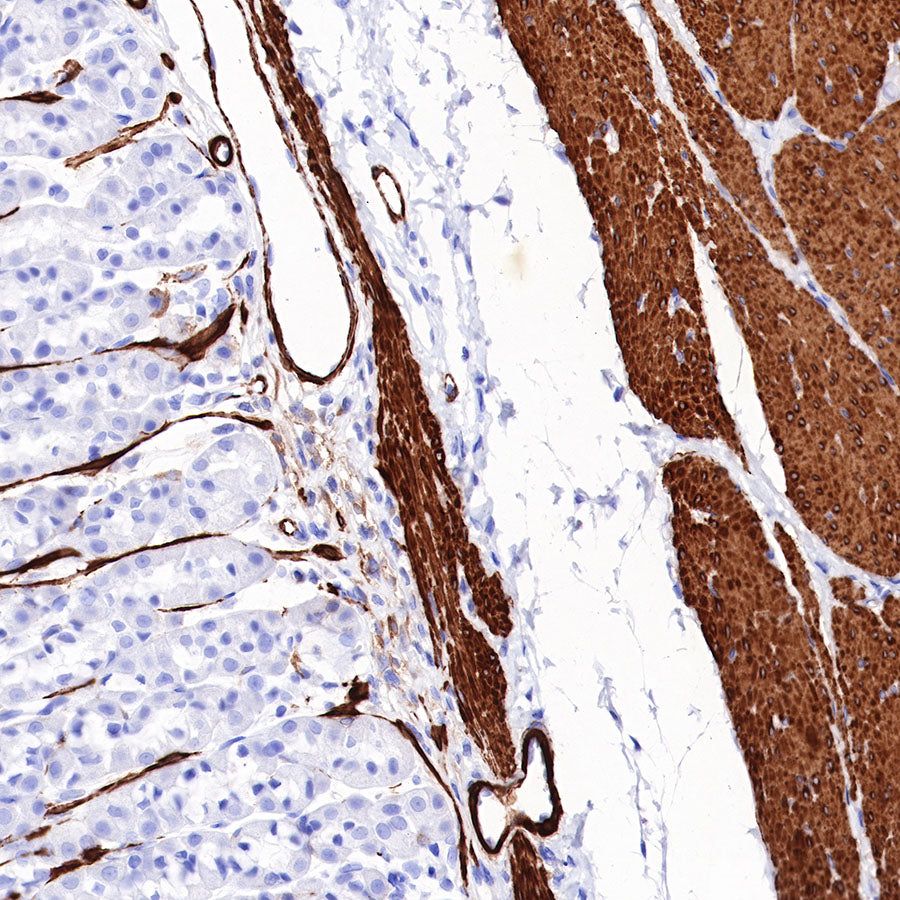

Western Blot
WB result of Myosin-11 Rabbit mAb Primary antibody: Myosin-11 Rabbit mAb at 1/25000 dilution Lane 1: mouse skeletal muscle lysate 5 µg Lane 2: mouse bladder lysate 5 µg Negative control: mouse skeletal muscle lysate Secondary antibody: Goat Anti-Rabbit IgG, (H+L), HRP conjugated at 1/10000 dilution Predicted MW: 227kDa Observed MW: 250kDa Exposure time: 30s
WB result of Myosin-11 Rabbit mAb Primary antibody: Myosin-11 Rabbit mAb at 1/1000 dilution Lane 1: mouse skeletal muscle lysate 20 µg Lane 2: mouse prostate lysate 20 µg Negative control: mouse skeletal muscle lysate Secondary antibody: Goat Anti-Rabbit IgG, (H+L), HRP conjugated at 1/10000 dilution Predicted MW: 227kDa Observed MW: 250kDa Exposure time: 60s
WB result of Myosin-11 Rabbit mAb Primary antibody: Myosin-11 Rabbit mAb at 1/25000 dilution Lane 1: rat skeletal muscle lysate 5 µg Lane 2: rat bladder lysate 5 µg Negative control: rat skeletal muscle lysate Secondary antibody: Goat Anti-Rabbit IgG, (H+L), HRP conjugated at 1/10000 dilution Predicted MW: 227kDa Observed MW: 250kDa Exposure time: 30s
Immunohistochemistry
IHC shows positive staining in paraffin-embedded human breast. Anti-Myosin-11 antibody was used at 1/1000 dilution, followed by a HRP Polymer for Mouse & Rabbit IgG (ready to use). Counterstained with hematoxylin. Heat mediated antigen retrieval with Tris/EDTA buffer pH9.0 was performed before commencing with IHC staining protocol.
IHC shows positive staining in paraffin-embedded human colon. Anti-Myosin-11 antibody was used at 1/1000 dilution, followed by a HRP Polymer for Mouse & Rabbit IgG (ready to use). Counterstained with hematoxylin. Heat mediated antigen retrieval with Tris/EDTA buffer pH9.0 was performed before commencing with IHC staining protocol.
IHC shows positive staining in paraffin-embedded human prostate. Anti-Myosin-11 antibody was used at 1/1000 dilution, followed by a HRP Polymer for Mouse & Rabbit IgG (ready to use). Counterstained with hematoxylin. Heat mediated antigen retrieval with Tris/EDTA buffer pH9.0 was performed before commencing with IHC staining protocol.
IHC shows positive staining in paraffin-embedded human stomach. Anti-Myosin-11 antibody was used at 1/1000 dilution, followed by a HRP Polymer for Mouse & Rabbit IgG (ready to use). Counterstained with hematoxylin. Heat mediated antigen retrieval with Tris/EDTA buffer pH9.0 was performed before commencing with IHC staining protocol.
IHC shows positive staining in paraffin-embedded human testis. Anti-Myosin-11 antibody was used at 1/1000 dilution, followed by a HRP Polymer for Mouse & Rabbit IgG (ready to use). Counterstained with hematoxylin. Heat mediated antigen retrieval with Tris/EDTA buffer pH9.0 was performed before commencing with IHC staining protocol.
IHC shows positive staining in paraffin-embedded human breast cancer. Anti-Myosin-11 antibody was used at 1/1000 dilution, followed by a HRP Polymer for Mouse & Rabbit IgG (ready to use). Counterstained with hematoxylin. Heat mediated antigen retrieval with Tris/EDTA buffer pH9.0 was performed before commencing with IHC staining protocol.
IHC shows positive staining in paraffin-embedded human leiomyosarcoma. Anti-Myosin-11 antibody was used at 1/1000 dilution, followed by a HRP Polymer for Mouse & Rabbit IgG (ready to use). Counterstained with hematoxylin. Heat mediated antigen retrieval with Tris/EDTA buffer pH9.0 was performed before commencing with IHC staining protocol.
Negative control: IHC shows negative staining in paraffin-embedded human cardiac muscle. Anti-Myosin-11 antibody was used at 1/1000 dilution, followed by a HRP Polymer for Mouse & Rabbit IgG (ready to use). Counterstained with hematoxylin. Heat mediated antigen retrieval with Tris/EDTA buffer pH9.0 was performed before commencing with IHC staining protocol.
Negative control: IHC shows negative staining in paraffin-embedded human skeletal muscle. Anti-Myosin-11 antibody was used at 1/1000 dilution, followed by a HRP Polymer for Mouse & Rabbit IgG (ready to use). Counterstained with hematoxylin. Heat mediated antigen retrieval with Tris/EDTA buffer pH9.0 was performed before commencing with IHC staining protocol.
IHC shows positive staining in paraffin-embedded mouse stomach. Anti-Myosin-11 antibody was used at 1/1000 dilution, followed by a HRP Polymer for Mouse & Rabbit IgG (ready to use). Counterstained with hematoxylin. Heat mediated antigen retrieval with Tris/EDTA buffer pH9.0 was performed before commencing with IHC staining protocol.
IHC shows positive staining in paraffin-embedded rat stomach. Anti-Myosin-11 antibody was used at 1/1000 dilution, followed by a HRP Polymer for Mouse & Rabbit IgG (ready to use). Counterstained with hematoxylin. Heat mediated antigen retrieval with Tris/EDTA buffer pH9.0 was performed before commencing with IHC staining protocol.
IF shows positive staining in paraffin-embedded human colon. Anti-Myosin-11 antibody was used at 1/125 dilution (Green). Goat polyclonal Antibody to Rabbit IgG - H&L (Alexa Fluor® 488) was used as secondary antibody at 1/1000 dilution. Counterstained with DAPI (Blue). Heat mediated antigen retrieval with Tris/EDTA buffer pH9.0 was performed before commencing with IF staining protocol.
IF shows positive staining in paraffin-embedded mouse colon. Anti-Myosin-11 antibody was used at 1/125 dilution (Green). Goat polyclonal Antibody to Rabbit IgG - H&L (Alexa Fluor® 488) was used as secondary antibody at 1/1000 dilution. Counterstained with DAPI (Blue). Heat mediated antigen retrieval with Tris/EDTA buffer pH9.0 was performed before commencing with IF staining protocol.